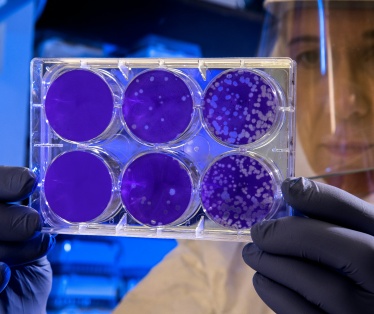

Ai e metaverso, parte Call4Innovit 2025
Torna per il terzo anno consecutivo Call4Innovit, il programma di accelerazione per piccole e medie imprese e start up innovative italiane nella Silicon Valley promosso dal Centro di Cultura e Innovazione italiano gestito da Fondazione Giacomo Brodolini ed Entopan Innovation negli spazi di Innovit, a San Francisco.
Come nelle scorse edizioni, le call copriranno l'intero arco del 2025 concentrandosi su sei temi chiave di innovazione: intelligenza artificiale per lo sviluppo di videogiochi; tecnologie immersive e del metaverso (Ai in game development, immersive technologies, metaverse); economia spaziale (space economy); scienze della vita; biotecnologie e longevità (lifeSciences, bioTech, longevity); tecnologie per la moda e la bellezza (fashionTech e beautyTech); hardware, robotica, Internet of Things e produzione intelligente (hardware, robotics, IoT e smart manufacturing); tecnologia pulita, per il settore agroalimentare e Blue Economy (cleanTech, agrifoodTech e BlueEconomy).
La prima scadenza dell'anno è fissata per il 29 gennaio 2025 e riguarderà sia le imprese che si occupano di intelligenza artificiale per lo sviluppo di videogiochi, tecnologie immersive e del metaverso che quelle interessate a partecipare allo Start Up Bootcamp, una open call rivolta alle start up attive in qualsiasi settore tecnologico.
A seguito di una selezione effettuata sulla base del merito, le start up e le pmi scelte avranno l'opportunità di partecipare a un programma di orientamento e mentorship online della durata di due settimane, ideato per prepararle alla crescita internazionale.
Successivamente, dopo un'ulteriore fase di selezione, un gruppo di imprese sarà invitato a San Francisco per un programma di accelerazione intensivo che avrà luogo a febbraio 2025 presso la sede di Innovit. Le attività includeranno workshop, sessioni di mentorship e accesso a opportunità di networking nell'ecosistema dell'innovazione della Bay Area.
Le candidature e la partecipazione al programma sono gratuite. Le spese di viaggio e di soggiorno a San Francisco sono a carico delle imprese partecipanti.